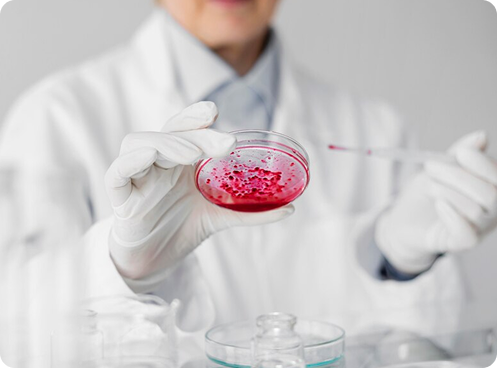
Research & Development

The Ultra-modern plant of products has a dedicated section for producing hygiene products, acquired area and build up area of over 6,000 sq.ft. With separate warehouses for raw materials and finished goods, our logistics team ensures inventory management for our clients.
Based in Surat, Gujarat, India, installed latest ultra modern designed production infrastructure technique & quality test @ every stage of production leads to the optimum quality of products. We continuously strive to satisfy every needs…
Our offered range has been brought forward after using latest technology and qualitative materials so that their efficient usage must be experienced in several industrial applications. These products are asked prominently as characterised by high tearing strength, solvent free properties, smooth texture and perfect finish. In the process, we have assorted world-class working facilities and hired effulgent team of professionals to bring forth our qualitative offerings, conveniently.
Our infrastructure is vast and organised where we perform our entire organisational tasks from sourcing of raw materials till the final dispatch. Our personnel have years of industry experience and are committed towards meeting our customer’s needs & requirements. As offering products to cater to several industry specific usages, today, we are known across the globe and are shipping products to customers in overseas market. Our customers are our prime consideration and for them, we are here engaged in conducting our profound business tasks. It has been possible for us to achieve market leadership with customer satisfaction & to offer them innovative, cost-effective and high quality products…
Various quality checks
advanced production unit
fully automated machines
To challenge global hygiene benchmark, advanced production unit, fully automated machines for best productions, various quality checks through scientific process, best research & laboratory, packing machine, ready inventory products in warehouse, precious products range for every age group, conference room, handling team strength, best technology & affordability to improve the quality of life of global community in lack of awareness & availability,
We keep in aim to a milestone foundation Navi Group having building blocks in Dahej JIDC to manufacture the health and hygiene products capacity of more than 350 million units monthly in future. we taking care of all activities bring progress to one & all, protecting the rights of others, while sacrificing our rights have been wheel of progress.
NAVI group is known for its principles & values having well experience history of more than 15 yrs of products ranges. since decades protecting the rights of others, while sacrificing our rights have been wheel of progress, during journey we taking care of all activities we bring progress to one & all. we have always worked towards progress and prosperity of every one associated of pan group, outwitting the competitions, we touch their products excellence and comforts of young healthy of new india. Infrastructure of 15 acres of land with 12000 sq. ft. super buildup area producing 250 millions per months. Our facilities to build best practices , classified area for raw materials and packed goods, positive pressure production , materials handling, Unidirectional materials movement, high efficiency, the best in class hygiene products, strigent quality check products with online offline machine vision check system at multiple points, highly trained engineers, R&D in-house dept. dedicated to make quality products gives superior quality, private level partners, we believe in adopting customers satisfaction with searching new customers on globe to furnish them. Retails counter, trade partners, e- commerce industry, name of trust, strong name in firmly growth industry. Swift delivery time line within 72 hrs across various ware house across nation, corporate & company is situated in Gujarat well connected by air, water and roadways, railways. Future Expansion plan of 1500 millions irrelevant passion of health team.
Innovation is the fuel to all growth our in-house R&D Facility fosters cutting-edge technological advancement. Our fully integrated Research & Development Unit is equipped with imported branded instruments to perform tests regarding various properties of the hygiene films.
All Hygiene products testing are conducted by our in-house laboratories using international standards. In addition to the standard MFI and Tensile tests, we also conduct Liquid penetration, rewetting, and open area tests to name a few.
In order to deliver a great customer experience, Manufacturing Supported by latest, state-of-art R&D technology, Navi has set up the manufacturing unit. Considering that we strongly believe in delivering the best, we make no compromises in either the quality of our products, or in our R&D investments.
In order to match the global standards, Navi Sanitary Napkins were designed after in-depth research that had stretched over a span of more than 15+ years. Developed and designed by US professionals with extensive experience in feminine hygiene, Navi Sanitary Napkins possess all premium features one would hope for. Similarly, our Health & Hygiene and Baby Care range has been manufactured in a way where quality comes first, and principles are respected.
Package and bundle wrapping machines are installed at the Finished Goods warehouse to meet JIT guidelines. All finished products are packed in a closed, sanitary work environment, branded with bar codes for convenient material tracking, and stored in our warehouse in accordance with industry standards.


Innovation drives our growth. Our fully integrated in-house R&D facility, equipped with advanced imported instruments, ensures high-quality hygiene film testing to international standards. We conduct MFI, tensile, liquid penetration, rewetting, and open area tests. Guided by globally experienced directors, our modern, dust-free production environment maintains strict cleanliness. Separate blending areas and enclosed processing zones prevent contamination, while scanners and cameras ensure zero-defect products that meet diverse customer needs.